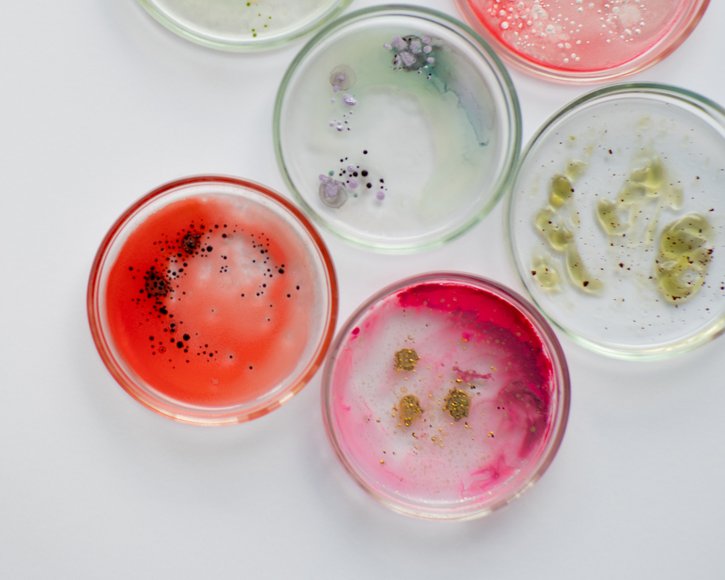
Zahl antibiotikaresistenter Erreger nimmt zu

Zahl antibiotikaresistenter Erreger nimmt zu
Die Weltgesundheitsorganisation (WHO) hat ihr Verzeichnis der Bakterien aktualisiert, bei denen gängige Medikamente häufig wirkungslos bleiben. Sie appelliert an Arztpraxen und an die Forschung.
Die wachsende Unempfindlichkeit von Krankheitserregern gegenüber vielen Antibiotika bereitet Fachleuten schon seit geraumer Zeit Sorge. Jetzt hat die WHO ihre Liste der problematischen Erreger erneut erweitert.
Antimikrobielle Resistenzen (AMR) verursachen laut WHO weltweit jährlich etwa fünf Millionen Todesfälle. Eine besondere Gefahr geht dabei von Erregern aus, die sich in Kliniken ausbreiten.
Forschung ist gefragt
Wie schon 2017 führt das Bakterium Acinetobacter baumannii die Prioritätenliste an. Es bedroht in Krankenhäusern insbesondere Patienten und Patientinnen mit geschwächtem Immunsystem und kann Lungenentzündungen (Pneumonien), Wund- und Weichteilinfektionen, Harnwegsinfekte, Blutvergiftung (Sepsis) sowie Hirnhautentzündungen hervorrufen. Ebenfalls gefährlich sind bestimmte Enterobakterien, die ähnliche Infektionen auslösen können. Neu in der Höchstkategorie findet sich Mycobacterium tuberculosis, der Hauptverursacher von Tuberkulose.
Die WHO bittet die Forschung eindringlich, die Entwicklung neuartiger Antibiotika zu forcieren. Zwar sind seit 2017 neun neue Antibiotika auf den Markt gekommen, jedoch handelte es sich meist um Variationen existierender Medikamente, gegen die Bakterien rasch erneut Resistenzen entwickeln. Zudem wirken nur wenige effektiv gegen multiresistente Bakterien, die gegen verschiedene Mittel unempfindlich sind.
Das Kernproblem besteht darin, dass Präparate gegen multiresistente Bakterien nur als letztes Mittel eingesetzt werden. Folglich bleibt der Markt relativ klein, was den Anreiz für Pharmaunternehmen verringert, solche Medikamente zu entwickeln.
Hinweise für MFA
Resistenzen entstehen leichter, wenn Antibiotika unnötig oder unsachgemäß (etwa zu kurz) eingenommen werden. Die Verantwortung für die Verordnung und die Aufklärung der Patienten und Patientinnen liegt zwar beim Arzt oder der Ärztin, aber viele Erkrankte kommen im Praxisalltag auf Sie als MFA mit Fragen zu. In diesen Fällen sollten Sie auf zwei Punkte deutlich hinweisen:
- Patienten und Patientinnen dürfen keinesfalls selbstständig Antibiotika einnehmen (die beispielsweise bei anderer Gelegenheit verschrieben wurden und deswegen zu Hause vorrätig sind).
- Die Einnahme muss strikt nach den Anweisungen des Arztes oder der Ärztin erfolgen – kein vorzeitiger Abbruch ohne Rücksprache, auch wenn sich die Beschwerden schnell verbessern oder Nebenwirkungen der Medikamente auftreten!
Quellen
Wöchentliche Neuigkeiten für den Praxisalltag
- Jeden Montag: 30 Minuten Live-Webinar
- Video-Aufzeichnung in der Mediathek





